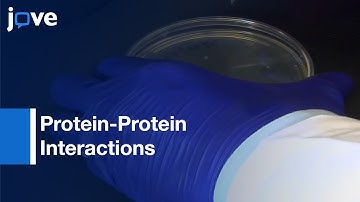
Probing High-Density Functional Protein Microarrays: Protein-Protein Interactions l Protocol Preview

⬇ DOWNLOAD NOW
Kalau muncul iklan pop-up, tutup lalu klik tombol kembali
Download lagu Lecture 24 : Applications of protein microarrays in deciphering PTMs and biological networks secara gratis hanya untuk keperluan promosi. Dukung artis favorit kamu dengan membeli musik original di iTunes atau platform resmi lainnya.
 Application of cell free expression protein microarrays in biomarker discovery
Application of cell free expression protein microarrays in biomarker discovery
 DNA Microarray (DNA chip) technique
DNA Microarray (DNA chip) technique
 Protein Microarray | Protein Arrays | Protein Biochips |
Protein Microarray | Protein Arrays | Protein Biochips |
 Lecture 16 : Applications of protein microarrays in Malaria Research-I
Lecture 16 : Applications of protein microarrays in Malaria Research-I
 Lecture 17 : Applications of protein microarrays in Malaria Research-II
Lecture 17 : Applications of protein microarrays in Malaria Research-II
 PEPperCHIP® Peptide Microarray Applications (with subtitles)
PEPperCHIP® Peptide Microarray Applications (with subtitles)
Probing High-Density Functional Protein Microarrays: Protein-Protein Interactions l Protocol Preview
Probing High-Density Functional Protein Microarrays: Protein-Protein Interactions l Protocol Preview
 Gene Expression Analysis and DNA Microarray Assays
Gene Expression Analysis and DNA Microarray Assays